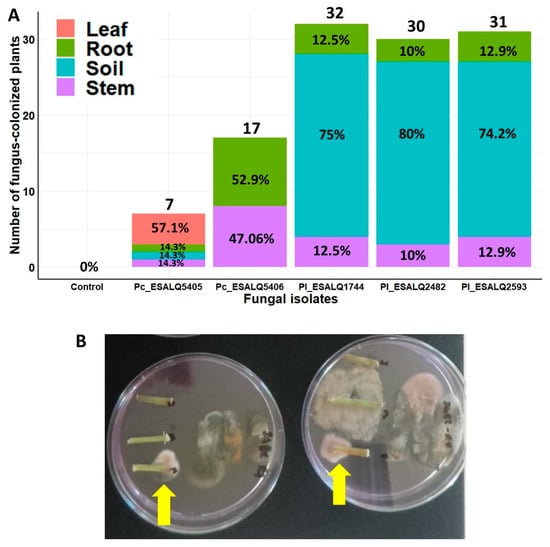

Abstract
Pochoniachlamydosporia and Purpureocillium lilacinum are fungal bioagents used for the sustainable management of plant parasitic nematodes. However, their production through submerged liquid fermentation and their use in seed treatment have been underexplored. Therefore, our goal was to assess the effect of different liquid media on the growth of 40 isolates of P. lilacinum and two of P. chlamydosporia. The most promising isolates tested were assessed for plant growth promotion and the control of the two-spotted spider mite (Tetranychus urticae) and the soybean cyst nematode (Heterodera glycines). Most isolates produced > 108 blastospores mL−1 and some isolates produced more than 104 microsclerotia mL−1. Microsclerotia of selected isolates were used to inoculate common bean (Phaseolus vulgaris L.) seeds in greenhouse trials. All fungal isolates reduced the T. urticae fecundity in inoculated plants through seed treatment, while P. chlamydosporia ESALQ5406 and P. lilacinum ESALQ2593 decreased cyst nematode population. Purpureocillium lilacinum was more frequently detected in soil, whereas P. chlamydosporia colonized all plant parts. Pochonia chlamydosporia ESALQ5406 improved the root development of bean plants. These findings demonstrate the possibility of producing submerged propagules of P. chlamydosporia and P. lilacinum by liquid culture, and greenhouse trials support the applicability of fungal microsclerotia in seed treatment to control P. vulgaris pests.
1. Introduction
In a broad sense, biological control seeks to reduce agricultural pests and plant pathogens by means of employing natural enemies, including microorganisms and macroorganisms, in alignment with the minimal risk posed to the environment and human health [1,2]. In 2019, the Brazilian biopesticide market showed a 70% increase in biological products registered for management of agricultural pests, which represented a landmark in the biological control history in Brazil [3]. The microbial control of pests is advantageous due to their narrower host spectrum and higher selectivity than traditional, broad-spectrum chemical pesticides [4]. Many of these beneficial microbes, such as fungi, viruses, protists, and bacteria, are valuable eco-friendly tools for the sustainable regulation or management of insects, mites, and plant–pathogen populations. Furthermore, microbes play an essential role in the mitigation strategy of pest resistance to chemical pesticides and have been ramped up due to the expansion of organic crop production worldwide [4].
Filamentous fungi of the order Hypocreales are recognized as potential biocontrol agents to combat numerous pests. Among those, the soilborne cosmopolitan fungi Purpureocillium lilacinum (Hypocreales: Ophiocordycipitaceae) and Pochonia chlamydosporia (Hypocreales: Clavicipitaceae) are currently used as microbial pesticides against plant-parasitic nematodes in Brazil [5,6]. Currently, there are 13 registered products against phytonematodes (nine of P. lilacinum and four of P. chlamydosporia) in Brazil, notably to control Meloidogyne spp. and Heterodera glycines [7]. Beyond their role as bionematicides, these fungi have also shown insecticidal and acaricidal activities [8,9]. Both P. chlamydosporia and P. lilacinum are commonly found in a wide variety of soils and naturally inhabit the rhizosphere of both native vegetations and crops. These fungi can produce and secrete extracellular hydrolytic enzymes involved in the colonization process of mature females, cysts, and egg masses of the sedentary plant-parasitic nematodes Heterodera spp. and Meloidogyne spp. Additionally, both P. chlamydosporia and P. lilacinum can establish endophytic associations with host plants, thus playing an essential role in plant growth promotion. These features bring desirable outcomes, such as induced resistance and tolerance to biotic and abiotic stresses by modulating host plant phytohormones, biochemical defense responses against the attack of pests and plant pathogens, and alleviation of abiotic stresses and the facilitation of nutrient uptake by colonized host plants [10,11].
In the development of novel biocontrol products, the production of fungal propagules can be accomplished by two main mass production methods: solid and submerged fermentations. In the first, a nutrient-poor substrate, usually with a low water activity, is employed to sustain growth at the interface with the atmosphere, allowing abundant oxygen supply for sporulation, resulting in the aerial conidiophores and conidia. Such asexual propagules consist of important fungal structures for dissemination and infection [12]. This method is easily carried out with low-cost equipment. The major hindrance to this production lies in the time required to produce aerial conidia. Generally, to achieve a high spore yield with this fermentation process takes 10 to 15 days or even longer, depending on the fungus species and isolate. At the same time, it is also dependent on large growth rooms with controlled environmental conditions, such as photoperiod and temperature. Notably, there is trouble in controlling fermentation parameters, such as pH, water activity, aeration, and nutrient levels during fungal growth, while the contamination risk may be more frequent due to the lack of automation.
On the other hand, the submerged liquid fermentation offers a versatile and cost-effective technological platform for various fungal propagules, enabling a shorter cultivation period (i.e., 2–5 days). This technology also allows higher yields, with standardized batch-to-batch uniformity, and greater control of environmental and nutritional growth conditions, in a process with lower contamination risk that is less labor-intensive [12,13]. The propagules produced by submerged liquid culture vary greatly across inter- and intraspecies of fungi. An interesting fungal structure for the pest control is the microsclerotium (hereinafter referred to as MS), a resistance structure that consists of a compact mass of dark-pigmented hyphal aggregates with a size in the range of 50 to 600 µm [14]. Submerged conidia (i.e., microcycle conidia) differ from aerial conidia and blastospores in structural and biochemical features, as the former can be originated from both hyphae or blastospores and shows intermediate hydrophobic and hydrophilic physicochemical characteristics, an adaptation in response to a nutritionally limited growth environment [15,16,17]. Following the penetration of the host through the cuticle, fungal cells are transformed into in vivo blastospores, which are hydrophilic, yeast-like vegetative cells produced by budding, septation, and/or fragmentation of the hyphae within the arthropod hemocoel. These yeast-like cells then continue to propagate by budding and/or fission, in a similar way to what occurs in true yeast cells [18,19,20]. They are also formed during in vitro growth by nutrient-rich and oxygen-rich culture conditions [21]. In contrast, submerged conidia are generally obtained by cultivation under nutritional-poor media [16].
Among the abovementioned fungal structures, there is particular interest in the MS, which are considered a promising alternative to aerial conidia, notably for seed coating and soil inoculation [22,23]. These structures are stable and resilient under field conditions and may remain viable until conditions become more favorable for growth [14]. MS are also more tolerant to adverse abiotic factors, such as UV-B and heat, compared to aerial conidia [24]. The impact of nutritional requirements of liquid media on such submerged propagules has not been investigated yet on the production performance of various isolates from these two nematophagous fungi. Hence, the present work attempts to shed light on the intraspecific phenotypic growth variability in response to varied liquid media compositions for the optimal production of MS and submerged blastospores.
The two-spotted spider mite Tetranychus urticae Koch (Acari: Tetranychidae) is among the most polyphagous and cosmopolitan pests of vegetable and legume crops that attacks the phyllosphere of numerous indoor and outdoor cropped plants, including common bean and soybean. Its chemical control is linked with a long history of evolving resistance to acaricides [25,26]. Another economically important global pest is the soybean cyst nematode Heterodera glycines Ichinohe (Nematoda: Tylenchida), which stands out as the most devastating parasite of soybean Glycine max (L.) Merr. The losses caused by this nematode can be up to one billion dollars for the U.S. economy annually and over 10 billion dollars worldwide [27].
To our knowledge, there is only one study that has investigated the production of MS of P. lilacinum by liquid culture along with its in vitro bionematicidal activity against the root-knot nematode Meloidogyne incognita, but there are no reports on outcomes from the seed inoculation and their effects on biocontrol activities in planta against the two-spotted mite and the soybean cyst nematode, along with growth promotion in common beans. None of these aspects has been explored for P. chlamydosporia. In this sense, there is a lack of studies concerning the intra- and interspecific variation in the production of MS and other submerged propagules of these two crucial biocontrol agents by liquid culture coupled to the investigation of seed treatment with MS as a potential inoculation method for inducing control of these two devastating pests from below and above ground, which has motivated the present study. It is also relevant to mention that there are no available products based on either liquid fermentation or the MS of fungal bionematicides worldwide.
In light of current knowledge, no published studies have addressed the application of the MS of P. chlamydosporia and P. lilacinum to common bean (Phaseolus vulgaris L.) seeds and their subsequent effects on the population growth of T. urticae and H. glycines. Hence, this research aimed to carry out an extensive screening of 42 indigenous Brazilian isolates of P. chlamydosporia and P. lilacinum by assessing their production of MS and submerged blastospores using different complex liquid media. Additionally, the best MS producers were further selected to assess their endophytic capability in P. vulgaris plants through seed inoculation and to further afford plant protection from damages caused by T. urticae and H. glycines in greenhouse trials.
2. Materials and Methods
2.1. Source of Fungi and Inoculum Preparation
The isolates used (Table 1) in this work belong to the Entomopathogenic Microorganisms Collection “Prof. Sérgio Batista Alves” of the Laboratory of Pathology and Microbial Control of Insects at the Department of Entomology and Acarology of the University of São Paulo (ESALQ-USP). The selected isolates were identified morphologically and molecularly through sequencing of the nuclear internal transcribed spacer region (ITS) of nuclear DNA with the primers ITS5 and ITS4 [28,29,30]. The evolutionary analysis was performed by a maximum likelihood method with a Kimura 2-parameter model and invariant sites using the software MEGA6 [31,32].

Table 1.
Description of the origin and collection date of Purpureocillium lilacinum and Pochonia chlamydosporia isolates used in the experiments.
The monosporic cultures from all isolates were made to obtain the inoculum. A standard inoculum used in all bioassays was prepared with aerial conidia, harvested from 10-day-old sporulated cultures grown on potato dextrose agar (PDA, Difco®) at 25 ± 1 °C with a 12:12 h (L:D) photoperiod.
The collection, maintenance, and use of these fungal isolates in the present study were conducted following the Brazilian National System of Management of Genetic Heritage and Associated Traditional Knowledge—“SisGen” approved under the protocol RAC856E.
2.2. Submerged Liquid Fermentation
Conidial suspensions were obtained from 15-day-old sporulated cultures grown on PDA plates by harvesting conidia with 10 mL of 0.04% aqueous solution of sorbitan monooleate (Tween® 80, Sigma-Aldrich, St. Louis, MO, USA), and then serially diluted to enumerate conidia using an improved Neubauer (hemocytometer) chamber at 400× magnification. All fungal isolates were standardized with aliquots of 5 mL containing 5 × 106 conidia mL−1, and were then added into baffled Erlenmeyer flasks (250 mL) (Glass, Bellco®, Vineland, NJ, USA) filled with 45 mL of liquid medium, thus adding up to 50 mL per flask. Inoculated liquid cultures were incubated in a rotary shaker with 300 revolutions per minute (rpm) at 28 ± 2 °C (MARCONI®, Model: MA 830, Piracicaba, SP, Brazil) in the dark. All culture flasks were shaken manually on a daily basis to prevent mycelial growth on the flask walls.
The liquid medium developed by Iwanicki et al. [33] arose from a combination of two other media described by Mascarin et al. [21] and by Adamék [34], and this was employed in this study to induce the production of blastospores and possibly submerged conidia. The second test medium had a C:N ratio of 10:1 and 36 g carbon L−1 (namely Jackson 4), in which the carbon source used was anhydrous glucose (45 g L−1, 20% w/v (40% total carbon), Êxodo Científica Química Fina Indústria e Comércio Ltd., Sumaré, SP, Brazil) supplemented with yeast extract (10% total nitrogen, Difco™, Sparks, MD, USA) as the nitrogen source (45 g L−1). The third medium used had a C:N ratio of 50:1 and 36 g carbon L−1 (namely Jackson 6, containing glucose 81 g L−1 and yeast extract 9 g L−1). Both media contained salts, trace metals, and vitamins in the basal medium, which was comprised of KH2PO4, 4.0 g L−1; CaCl2•2H2O, 0.8 g L−1; MgSO4•7H2O, 0.6 g L−1; FeSO4•7H2O, 0.1 g L−1; CoCl2•6H2O, 0.1 g L−1; MnSO4•H2O, 0.016 g L−1; ZnSO4•7H2O, 0.014 g L−1; thiamine, riboflavin, calcium pantothenate, niacin, pyridoxine, thioctic acid, 500 µg L−1 each; and folic acid, biotin, vitamin B12, 50 µg L−1 each. The modified Adamék medium was prepared with glucose (40 g L−1) as a carbon source, yeast extract (80 g L−1) and corn steep liquor (40 g L−1) as nitrogen sources, and a basal medium containing salts, trace metals, and vitamins as mentioned above. Two, three, and four days after fungal inoculation in the culture media, 1 mL samples were taken under aseptic conditions and were diluted with distilled water + 0.04% Tween® 80 (1:10) to evaluate the concentration of MS on glass slides (25 × 75 mm) (using 50 µL of culture diluted samples) and to examine the culture morphology. Only pigmented MS larger than 50 µm in diameter were counted [14]. For the modified Adamék medium, blastospore concentration was determined for all isolates (see fungal propagules considered in Figure A1).
2.3. Drying Fungal Propagules after Submerged Production
Selected isolates were cultivated by submerged fermentation for four days, and then their whole biomass (crude broth) was mixed with diatomaceous earth (DE, 5% w/v) (Sigma-Aldrich, St. Louis, MO, USA). This mixture was dewatered through filter paper (110 mm diameter, pore size 8 µm, Unifil®, Campo Limpo Paulista, SP, Brazil) under vacuum filtration [35]. The final material was transferred to Petri dishes (90 × 15 mm) and submitted to a slow drying process (20 h at 50–60% of relative humidity (R.H.) and an additional 1–2 h at 15–20% R.H.). After reaching water activity ≤ 0.2 measured in the LabMaster-aw equipment (Novasina®, Lachen S.Z., Switzerland), samples of 25 mg were immediately used to assess MS viability, and the remainder was vacuum packaged in polyethylene bags and stored at 5 °C until use in further experiments.
For MS viability assessment, 25 mg of MS + diatomaceous earth (MS + DE) was sprinkled on water-agar medium (2% w/v) in Petri dishes (90 × 15 mm), and then incubated in a growth chamber at 28 °C in the dark. After 24 h of incubation, microsclerotial myceliogenic germination was assessed by randomly counting 100 granules with or without the formation of hyphae under a phase-contrast microscope (DM4000B, Leica® Microsystems, Wetzlar, Germany) [14,35]. The same plates were kept in a growth chamber for an additional seven days to evaluate the sporogenic germination resulting from aerial conidia produced per gram of granules (i.e., conidia g−1 of MS + DE). To accomplish this, conidia from sporulated granules on agar-water plates were harvested and serially diluted in 0.04% Tween 80® aqueous solution and were then counted in a Neubauer chamber at 400× magnification.
2.4. Seed Treatment of Beans with Nematophagous Fungi, Endophytism, and Growth Promotion
This study sought to assess the endophytic potential and growth promotion in common bean plants through seed treatment using two isolates of P. chlamyhdosporia and three isolates of P. lilacinum. Initially, seeds of the common bean cv. ‘IAC Milênio’ were surface-sterilized for 45 s in 70% ethanol, followed by 1 min in 1.5% of commercial sodium hypochlorite, for 45 s on 70% ethanol, and washed three times with distilled water [36]. The bean seeds were then coated with MS + DE granules of each selected isolate of P. lilacinum (ESALQ1744, ESALQ2482, and ESALQ2593) and P. chlamydosporia (ESALQ5405 and ESALQ5406). There was no significant variation between these fungal isolates for spore production by microsclerotial granules (F = 0.86, df = 4, 25, p = 0.503), and these yields fell in the range of 3.44 ± 0.55 to 4.78 ± 0.55 × 109 (mean ± S.E.) conidia g−1 of air-dried MS granules. The MS concentrations were standardized across fungal isolates by estimating the amount of MS required to deliver a field dosage of 1012 conidia ha−1, according to the conidia production yields obtained by sporulated MS granules upon re-hydration. To improve the adhesion of MS + DE granules to the seed surface, Arabic gum was added at 0.5% (w/w) to the MS granules during seed coating at a rate equivalent to 400 g Arabic gum to 100 kg of seeds. For this purpose, the mixture with Arabic gum was hydrated with sterile distilled water (approx. 150–200 µL mixed with 0.135–0.140 g of Arabic gum) for better adherence to the seeds. The control consisted of only common bean seeds treated with Arabic gum. Treated seeds were placed on a filter paper (110 mm diameter, pore size 8 µm, Whatman®, Little Chalfont, UK) to dry out the excess water, then these seeds (ten seeds per treatment) were sown in 1-L plastic pots filled with non-sterile (natural) potting mixture containing approx. 1.2 kg of 40% sand and 60% soil. Potted bean plants were kept in a greenhouse (22°42′46.4″ S; 47°37′36.3″ W) and were watered daily with tap water if necessary.
The entire experiment was repeated three times on different occasions under greenhouse conditions. A randomized block design was used with ten biological replicates (e.g., potted plants) for each treatment and a total of six treatments (control and five fungal treatments). An illustrative schematic procedure of seed treatment and the experimental setup is available in Figure A2.
At the end of the trial (45 days after fungal inoculation and seeding), the plants were removed from the pots, and their roots were washed to remove the soil. Measurements of the height of the aerial part (cm), root length (cm), and dry weights (g) of potted bean plants were carried out. In parallel to that, three fragments of roots, stems, and leaves were taken from each 45-day-old potted plant to assess the fungal colonization ability within the host plant tissues (i.e., endophytism). Pieces of plant parts were surface-sterilized by means of the following steps: immersion in 70% ethanol for 30 s, 1.25% commercial sodium hypochlorite for 60 s, 70% ethanol for 30 s. They were then rinsed in sterile distilled water three times before plating. Subsequently, aliquots of 50 µL of the last rinsing water were collected at the beginning and end of the sterilization process and were plated on PDA medium to confirm the success of the sterilization [37]. Surface-sterilized fragments of roots, stems, and leaves were placed on sterile filter papers to remove the excess water. These plant pieces were then plated on PDA medium amended with 0.5 g L−1 of cycloheximide, 0.2 g L−1 of chloramphenicol, 0.5 g L−1 of Dodine (65% w/v Dodex® 450 SC, Sipcam Nichino Brasil S/A, Uberaba, MG, Brazil), and 0.01 g L−1 of crystal violet (Dinâmica Química Contemporânea & Reagentes, Indaiatuba, SP, Brazil) [37]. These inoculated agar plates were incubated in a growth chamber for 20 days until fungal outgrowth was evident from those plant pieces. Fungal colonization was visually examined based on colony morphology under a microscope to identify fungal structures. For the soil analysis, 1 g of soil was diluted in 10 mL of distilled water + 0.05% Tween® 80, and then 50 µL aliquot of the dilutions 10−1, 10−2, and 10−3 were plated on the same selective medium and incubated at 25 ± 1 °C, 12:12 h L:D for 15 days. The colonies were morphologically examined under a phase-contrast microscope to identify both species of nematophagous fungi tested in this experiment.
2.5. Effects of Nematophagous Fungi on the Population Growth of the Two-Spotted Spider Mite
In this part of the study, the impact of fungal endophytes on the population growth of the two-spotted spider mite was evaluated in bean plants whose seeds were inoculated with air-dried MS granules of five selected nematophagous fungal isolates (seed treatment described in Section 2.4.) One transparent plastic clip cage (4.5 cm high × 3.8 cm diameter) with a mesh at the top (0.09 mm mesh size) was placed on each bean plant in the V4 stage, approximately 21 days after fungal inoculation and seeding [38]. Subsequently, one T. urticae female was individually transferred to each clip cage. The spider mite fecundity was estimated on the 7th day of infestation by counting the number of eggs, and eventually, any larvae emerged and were thus expressed as the number of eggs produced by mite or fecundity, as a means to measure the population growth of this mite. Treatments were set up using a randomized complete block design with ten plants (biological replicates) per treatment. The control group was represented by fungus-free bean plants only infested with the spider mite. The entire experiment was independently repeated three times using new fungal inoculums freshly obtained from different production and drying batches.
2.6. Effects of Nematophagous Fungi on the Soybean Cyst Nematode
The H. glycines ‘race 3’ populations used in the greenhouse experiments were provided by the Laboratory of Nematology, located at the Department of Plant Pathology and Nematology (ESALQ/USP). The inoculum consisted of a suspension containing 1000 individuals (eggs + second-stage juveniles [J2]) and was obtained from soybean plant roots, which were previously inoculated and maintained in a greenhouse. The H. glycines cysts were extracted following the method proposed by Machado and Silva [39]. They were manually ground in a 500-mesh sieve using a rubber and were then collected and transferred to a beaker.
Prior to the inoculation, the nematode suspension was homogenized using a magnetic stirrer. Each experimental unit (1-Lplastic pots filled with approx. 1.2 kg of natural (non-sterile) 40% sand and 60% soil potting mixture containing a common bean plant at V4—approx. 15 days after seeding) was inoculated with the nematode suspension by pouring it into two holes (2 cm and 4 cm depth) close to the plant stem. Vermiculite was added to the holes to avoid heat stress, and after the inoculation, the plants were transferred to the greenhouse until the evaluation.
The evaluation process occurred 45 days after the fungal inoculation and seeding [40]. The nematodes were extracted following the methodology described by Coolen and D’Herde [41]. The bean plants were removed from the pots, and the roots were carefully washed and cut into 1 cm pieces. The fragments were blended using a 1% commercial sodium hypochlorite to dissolve the eventual egg masses. The obtained nematode suspension was poured through two sieves, the first of 60 mesh (0.260 mm—to retain the coarse particles) and the second of 500 mesh (0.025 mm—to keep fine particles). The nematodes were collected in a beaker and centrifuged twice. In the first one, kaolin was added to each sample, followed by centrifugation at 1800 rpm for 5 min. In the second, the supernatant was discarded, and a sucrose solution (1.15 g cm−3) was added, followed by centrifugation at 1800 rpm for 1 min. The nematodes were collected using a 500 mesh sieve, and were then killed in low heat (approx. 50–60 °C) and fixed by adding 300 µL of formaldehyde. Samples were stored in the fridge (8 °C) until further analysis.
The number of nematodes was estimated by performing two 0.5 mL counts on a Peters’ counting slide under an optical microscope. After that, the final population and nematodes per gram of root were estimated from the total fresh root mass collected in each potted plant. A randomized block design was used with ten biological replicates (e.g., potted plants) for each treatment and a total of six treatments (control and five fungal treatments). This study was carried out in two independent greenhouse trials set up on different occasions using freshly produced fungal and nematode inoculums.
2.7. Data Analysis
The microsclerotia production of P. lilacinum and P. chlamydosporia were analyzed using Poisson generalized linear mixed models (GLMMs), including the effects of the experiment, isolate, day, medium, and the two and three-way interactions between isolate, day, and medium as fixed, as well as random day effects per experimental unit, medium and isolate combination, and an observational-level random effect of accounting for overdispersion. A linear mixed model was fitted to the logarithm of the submerged propagules yield, including the effects of the experiment, isolate, day, and the interaction between isolate and day as fixed and random day effects per experimental unit in the linear predictor. In this case, we also modeled the variance as a function of isolate to account for variance heterogeneity. The significance of the effects was assessed using likelihood-ratio tests at p < 0.05. As a complementary approach, we carried out an analysis that allowed us to look at the marginal performance of fungal isolates as random effects, regardless of medium and day of fermentation, in which we were able to establish a ranking order from the best to the weakest producers of MS and submerged blastospores.
Hierarchical clustering analysis was performed using microsclerotia and submerged propagules data for multiple fungal isolates. Predicted means derived from model fits were normalized before obtaining the Euclidean distances, a similarity measure. Subsequently, the distances were clustered, taking into account measurements for liquid media and fungal isolates using Ward’s method. We then produced a heat map using the ‘gplots’ package [42].
The female fecundity (number of eggs laid by each spider mite female up to seven days upon feeding on bean leaves) data were analyzed by fitting a Poisson model using the log link function. The additive effects of experiment and treatment were included in the linear predictor. The significance of the effects was assessed using Chi-squared tests for the difference between deviances. Multiple comparisons were performed by obtaining the 95% confidence intervals for the estimated treatment effects and the Tukey HSD method using the package ‘emmeans’ [43].
The soybean cyst nematode final population and the number of nematodes per gram of fresh root mass were fitted to generalized additive models (GAMS) with Gumbel distribution for errors and log-link function and included the isolate effect in the linear predictor [44]. When a treatment effect was found to be significant, then a likelihood ratio test was employed to compare each fungal treatment directly with the untreated control group (p < 0.05) to check whether the fungus was able to reduce the nematode population growth.
All plant trait variables (plant responses to fungal isolates) were analyzed independently for each experiment performed under greenhouse conditions using linear mixed models, including fungal isolate as a fixed effect and potted plant as the random effect in the linear predictor. The response variables recorded after 45 days of bean plant growth in the greenhouse encompassed aerial root length, plant height, whole plant dry weight, root, and foliage dry weight. The significance of the effects was assessed using F tests. Significant differences between treatments were determined by multiple comparisons based on contrast using the Tukey HSD method with 5% of significance with the package ‘emmeans’ [43].
Goodness-of-fit for model selection was assessed using half-normal plots with a simulated envelope [45] and wormplots [44]. All analyses were carried out using R [46].
3. Results
3.1. Microsclerotia (MS) Production
The majority of P. lilacinum and P. chlamydosporia isolates produced MS when cultivated in three different liquid culture media: modified Adamék, Jackson 6 (C:N ratio 50:1), and Jackson 4 (C:N 10:1). The exception here was noted for isolates ESALQ1907 (did not produce on Jackson 4 and 6), ESALQ1908 (did not produce on modified Adamék), and ESALQ2509 (did not produce on modified Adamék and Jackson 4) (Figure 1A). The mature microsclerotia from four-day-old cultures exhibited darker pigmentation when grown in the modified Adamék medium than the other tested media, as the former is richer in nitrogen and iron sulfate.

Figure 1.
Boxplots (colored symbols are mean values and bold horizontal lines are medians for fungal isolates within each liquid medium) and heatmaps representing the estimated means of microsclerotia (MS) production across the 42 fungal isolates of Pochonia chlamydosporia and Purpureocillium lilacinum grown in three different liquid media (modified Adamék, Jackson-4, and Jackson-6), from day 2 to 4 (A–D, respectively). The ranking graph depicting a gradient from strongest to weakest fungal isolate producers based on the estimated general mean of MS concentration (E). The scale from blue to red means that high MS are highlighted in red, whereas low MS yields are assigned with blue. Typical 4-day-old liquid-grown MS of P. lilacinum ESALQ1996 and P. chlamydosporia ESALQ5405 (F).
The MS production differed among culture media, and the concentration also varied among isolates and cultivation time (Figure 1B–D). For the Jackson 4 medium, the production ranged from 2 × 103 to 1.7 × 104 MS mL−1; and the most productive isolates in this medium were ESALQ1906, ESALQ1909, ESALQ2164, ESALQ2166, ESALQ2482, ESALQ2593, ESALQ2599 and ESALQ2765 (1.0–1.70 × 104 MS mL−1), and the ones with the lowest MS mL−1 concentration was attributed to ESALQ668 and ESALQ2832 (2 × 103 MS mL−1).
For the Jackson 6 medium, production ranged between 3 × 102 and 6 × 104 MS mL−1, with the most productive isolates being ESALQ1744, ESALQ1771, ESALQ2164, ESALQ2599, ESALQ2645 (1.0–1.96 × 104 MS mL−1), ESALQ2482 (6.1 × 104 MS mL−1) and ESALQ2593 (2.2 × 104 MS mL−1). On the other hand, the isolate ESALQ5406 was ranked the weakest producer (3.3 × 102 MS mL−1).
In the modified Adamék medium, yields of MS ranged from 1 × 103 to 2 × 104 MS mL−1 on the fourth day of fermentation, where five isolates stood out as the most productive ones: ESALQ2078, ESALQ2164, ESALQ 2509, ESALQ2593, and ESALQ2718 (1.0–1.16 × 104 MS mL−1). Conversely, the lowest numbers of MS were attained by isolates ESALQ668, ESALQ1996 and ESALQ2776 (1.66 × 103 MS mL−1). Besides that, isolate ESALQ5406 appeared to be recalcitrant when grown in this medium, as it did not produce any MS.
According to the estimated general mean of the ranking graph (Figure 1E) for fungal isolates based on all media and fermentation time, the three isolates with the highest rank that stood out were: ESALQ2482, ESALQ2164, and ESALQ2593 of P. lilacinum. On the other hand, the three isolates considered the least productive were ESALQ5406, ESALQ5405, and ESALQ2776. In comparison to P. lilacinum, P. chlamydosporia isolates (ESALQ5406 and ESALQ5405) did not perform well regarding MS production in any culture media, which reflected in productions ranging from 3.3 × 102 to 7 × 103 MS mL−1. All MS formed by these nematophagous fungi by day four of cultivation appeared well-formed and pigmented, depicting a compact hyphal aggregation within the size range of 50–600 µm (Figure 1F).
3.2. Submerged Blastospore Production
In the modified Adamék medium, the concentration of blastospore-like propagules was observed in larger numbers that increased over time in all fungal isolates (Figure 2A,B). Looking at the marginal performance of isolates corrected by experiment and fermentation day (Figure 2B,C), it was possible to rank the strongest to weakest producers of submerged propagules among the isolates tested. In this regard, the two P. chlamydosporia isolates, ESALQ5405 followed by ESALQ5406, showed the highest production yields of blastospores, while the weakest producer was the isolate P. lilacinum ESALQ1909. These results also corroborate the heatmap output and facilitate the selection of the best fungal isolates. Interestingly, the production of submerged conidia for these fungal isolates grown in any of the three liquid media tested here was not observed.

Figure 2.
Boxplots (colored symbols are mean values and bold horizontal lines are medians for fungal isolates within each fermentation day) and heatmap and a graph rank depicting a gradient between strongest and weakest fungal isolate producers for predicted mean concentration of submerged propagules (blastospores) of Purpureocillium lilacinum and Pochonia chlamydosporia on the fourth day of cultivation in the modified Adamék medium (A,B, respectively). Scale from blue to red means that high yields of submerged propagules are highlighted in red, whereas low yields are assigned with blue (C).
3.3. Effect of Nematophagous Fungi on Bean Growth through Seed Treatment
There was a significant variation among greenhouse trials regarding the plant traits evaluated after 45 days of growth. Several characteristics did not differ statistically from control plants, which include the mass of aerial portion (Trials 1, 2, and 3), total plant mass (Trials 1, 2, and 3), and plant length (Trials 1, 2, and 3) (Figure 3). However, differences among the strains are evident (Figure 3). For example, no statistical differences were obtained in length compared to control plants, but ESALQ2482 differed from ESALQ2593 (Trial 1).

Figure 3.
Common bean (Phaseolus vulgaris) plant traits (dry weight of the aerial part, total plant dry weight, root dry weight, plant height, root length) after seed treatment with different isolates of Purpureocillium lilacinum (ESALQ1744, ESALQ2482, and ESALQ2593) and Pochonia chlamydosporia (ESALQ5405 and ESALQ5406) at 45 days after fungal inoculation and seeding, under greenhouse conditions. Colored symbols inside boxplots represent means (±S.E., n = 10 plants per experiment and treatment), and treatments with no letters in common are statistically different at p < 0.05 based on Tukey HSD. Plant traits evaluated: dry weight of aerial part (g, DW_AP), dry weight of whole plant (g, DW_Plant), dry weight of roots (g, DW_root), plant height (cm), and root length (cm).
A decrease in the weight of the aerial part of the plants was observed for P. chlamydosporia isolates in trial 2 (p < 0.05), but the isolates of P. lilacinum were grouped with the control (Figure 3). In the same trial, plants treated with P. chlamydosporia presented a lower weight than plants treated with P. lilacinum ESALQ1744 (Figure 3).
An increase in root mass was obtained in trial 2 (Figure 3), in which all isolates of P. lilacinum and P. chlamydosporia differed statistically from the control (p < 0.05). In trial 3, all isolates were statistically similar to the control, although variability can be observed among the strains. Furthermore, it is important to highlight a tendency of root mass increasing of ESALQ1744 and ESALQ5406, which differed statistically from isolates ESALQ2593 and ESALQ5404, but not from the control plants.
Regarding plant height, no statistical difference was obtained in trial 1 and trial 2. In trial 3, an increase was obtained in plants treated with P. lilacinum ESALQ2593, which differed statistically from the control (p < 0.05). In the same trial, a trend of increased height was observed for the other isolates, but they did not differ statistically from both control and ESALQ2593.
3.4. Fungal Colonization in Potted Bean Plants
The endophytic ability of these nematophagous fungal isolates in potted bean plants was confirmed after seed inoculation with their MS. The spatial distribution of this endophytic relationship between fungal isolates and bean plants was measured as the incidence of the fungus in different plant parts. The persistence of these isolates in the potting soil was also determined by the incidence of the fungus in soil samples. There was a strong interaction between fungal isolate and substrate (plant parts and soil) on the incidence of fungal colonization from the bottom-up in potted bean plants (χ2 = 100.88, df = 15, p < 0.0001). In that way, the five fungal isolates (three of P. lilacinum and two of P. chlamydosporia) were able at different levels to endophytically colonize different parts of bean plants. All five fungal isolates colonized bean roots (10–52.9%), but only isolate P. chlamydosporia ESALQ5405 was not retrieved from the potting soil (Figure 4A). No nematophagous fungi were recovered from untreated control plants, even though the soil was not sterile, indicating the absence of natural resident endophytic fungi. Notably, the highest incidence of endophytism was detected in bean roots, followed by stem (10–47.06%) and leaf (0–57.1%). The three isolates of P. lilacinum were recovered from the stems and roots of bean plants, and they were also more frequently detected in potting soil than the two isolates of P. chlamydosporia (Figure 4A,B). In contrast, both isolates of P. chlamydosporia were either null or detected with low frequency in the soil (Figure 4A). Interestingly, P. chlamydosporia ESALQ5405 was the only fungus retrieved from leaf fragments and capable of colonizing all plant parts and the soil, whereas the other isolate—ESALQ5406—was only detected in roots and stems. These results indicate phenotypic variations in the spatial distribution of plant endophytism and soil competence among these fungal isolates.
Figure 4.
Spatial distribution and frequency of endophytic colonization after seed treatment with Purpureocillium lilacinum (Pl) and Pochonia chlamydosporia (Pc) within different plant tissues from potted bean plants and from the potting soil after 45 days of fungal inoculation and seeding under greenhouse conditions (A). Selective medium showing bean stem fragments endophytically colonized by P. lilacinum (indicated by yellow arrows) in (B). The total number of plants evaluated per treatment: n = 3 experiments × 4 structures × 10 repetitions = 120 plants.
3.5. Effects of Nematophagous Fungi on Population Growth of T. urticae
The effect of fungal isolates through seed coating in grown common bean plants exposed to two-spotted spider mites was measured by the production of eggs per leaf. As shown in Figure 5, the indirect acaricidal effect exerted by all P. chlamydosporia and P. lilacinum isolates was significant, as these fungi induced a striking reduction in the egg numbers laid by spider mite females (χ2 = 257.97, df = 5, 113, p < 0.0001). No differences were observed among these fungal isolates, which implies that they were similarly effective in suppressing T. urticae offspring (Figure 5).

Figure 5.
The number of eggs laid by Tetranychus urticae after seven days of infestation in bean plants derived from seeds inoculated with six different treatments: fungus-free control (0.5% w/v of Arabic gum) and fungal treatments based on seed-coating with MS (dose equivalent 1012 conidia ha−1) of the isolates ESALQ1744, ESALQ2482 and ESALQ2593 of Purpureocillium lilacinum (Pl), and isolates ESALQ5405 and ESALQ5406 of Pochonia chlamydosporia (Pc). Means (± 95% confidence interval, n = 20 biological replicates from two independent experiments) of spider mite counts (eggs per leaf arena). Treatments (vertical bars) followed by distinct letters differ significantly at p < 0.05 based on Tukey HSD.
3.6. Effects of Nematophagous Fungi on the Population Growth of H. glycines
Two independent greenhouse trials were carried out to assess the impact of isolates of two nematophagous fungal species against H. glycines in potted bean plants. Since these two experiments were conducted at different periods of the year, they greatly varied in terms of temperature, relative humidity, and photoperiod, and also exhibited a significant difference in magnitude between trials regarding the final nematode population in untreated plants (Trial 1: 507 nematodes versus Trial 2: 142 nematodes). Regarding the H. glycines final population, there was a significant effect in decreasing the nematode numbers displayed by isolates P. chlamydosporia ESALQ5406 and P. lilacinum ESALQ2593 when compared to control plants infested only with H. glycines in the first (χ2 = 12.75, df = 5, p = 0.0258) and the second trial (χ2 = 15.34, df = 5, p = 0.0090) (Figure 6). Consistently, these two nematophagous fungal isolates significantly reduced the final nematode population by approximately 2-fold and 3.5-fold compared to untreated plants infested with H. glycines, respectively. The other fungal isolates did not have a meaningful effect on the reduction of the final nematode population. Interestingly, bean plants treated with the isolate P. lilacinum ESALQ1744 portrayed a similar trend to that found in untreated plants. Actually, untreated plants had an increase in population growth of H. glycines, while P. lilacinum ESALQ1744 was unsuccessful in reducing nematode reproduction in both trials.

Figure 6.
Impact of Purpureocillium lilacinum (Pl) and Pochonia chlamydosporia (PC) isolates on the final population of the soybean cyst nematode Heterodera glycines in total fresh root mass from potted bean plants at 45 days after fungal inoculation and seeding under greenhouse conditions. Means with 95% confidence intervals (n = 10 plants per treatment in red symbols) followed by asterisks (*) are significantly different from untreated control plants infested only with the cyst nematode (Likelihood ratio test at p < 0.05).
Regarding the number of nematodes per gram of plants, all isolates of both fungal species reduced considerably the nematode density compared to control plants infested only with H. glycines in the first trial (χ2 = 29.78, df = 5, p = 0.00002). In the second trial, both isolates of P. chlamydosporia (ESALQ5406 and ESALQ5405) and one isolate of P. lilacinum (ESALQ2593) displayed a strong suppression effect in nematode density in comparison to uninoculated plants (χ2 = 13.64, df = 5, p = 0.01808) (Figure 7). Notably, in the first trial, when infested plants from untreated control exhibited higher population density of H. glycines (e.g., 1061 nematodes g−1 of roots), all nematophagous fungal isolates were capable of suppressing this parasite growth by 2.6–7.3-fold in comparison to untreated plants. The lowest nematode density was attained by P. lilacinum ESALQ2593 (e.g., 146 nematodes g−1 of roots). In the second trial, both isolates of P. chlamydosporia (e.g., 25.1–25.3 nematodes g−1 of roots) and the isolate of P. lilacinum ESALQ2593 (e.g., 36.2 nematodes g−1 of roots) were consistently effective at reducing nematode population density in bean roots by a magnitude of 1.2–2.8-fold lower nematodes than in untreated plants (e.g., 70.1 nematodes g−1 of roots).

Figure 7.
Impact of Purpureocillium lilacinum (Pl) and Pochonia chlamydosporia (PC) isolates on the population density (nematodes per gram of fresh root mass) of the soybean cyst nematode Heterodera glycines from potted bean plants at 45 days after fungal inoculation and seeding, under greenhouse conditions. Means with 95% confidence intervals (n = 10 plants per treatment in red symbol) followed by asterisks (*) are significantly different from untreated control plants infested only with the nematode (Likelihood ratio test at p < 0.05).
4. Discussion
The present study shows the potential of producing novel propagules of two key nematophagous fungi—P. chlamydosporia and P. lilacinum—by submerged liquid fermentation and to explore them for the biocontrol of economically important agricultural pest species. The potential of these fungi to control plant–parasitic nematodes is well known, but here we revealed their potential to also manage spider mites. Despite their phylogenetic distance and multiple ecological roles, both fungi are widely recognized as plant-growing promoting fungi (PGPF), in which they can directly act against plant pathogens or increase plant fitness by colonizing the root system [47,48,49]. Often, this colonization by endophytic fungi results in growth promotion, nutrient uptake, and induced resistance against biotic and abiotic stresses [50,51]. Therefore, acquiring high-quality propagules through a cost-effective mass production system is imperative to achieve multifunctional fungal biopesticides, once they are valuable additional tools in sustainable crop pest management programs.
Liquid fermentation provides many advantages when compared to traditional solid fermentation, including labor-saving, less time-consumption, and more controllable growth conditions [12,13]. In our results, 0.1–1.0 × 105 MS mL−1 and 1.0–1.2 × 109 yeast-like blastospores mL−1 were obtained by the best isolates of P. lilacinum and P. chlamydosporia within only four days of cultivation. To the best of our knowledge, this is the first comprehensive study investigating the impact of different liquid media on several isolates of P. lilacinum and P. chlamydosporia for the production of blastospores and MS by liquid culture. In agreement with our results, Song et al. [52] were the first to describe the ability of P. lilacinum to form persistent MS and the indispensable role of iron in its formation during liquid cultivation, and further showed that this type of propagule attains excellent nematophagous ability and greater thermotolerance and UV-B radiation tolerance compared to aerial conidia produced by solid substrate fermentation. However, the production of blastospores by P. lilacinum in liquid culture remains underexplored up to now. Microsclerotia (MS) and blastospores of P. chlamydosporia are preferred propagules to replace aerial conidia or chlamydospores. The results shown here open opportunities to explore submerged propagules of both species of nematophagous fungi for crop protection and growth promotion in agricultural production systems that may contribute to a reduction in reliance on chemical inputs.
A mass production through cost-effective and efficient submerged liquid fermentation of nematophagous fungi represents a groundbreaking advance for making these biocontrol agents economically viable and industrially scalable at a competitive cost compared to conventional solid-state fermentation currently practiced in developed and developing countries. To illustrate the relevance and demand for biological nematicides, most of the microbial biopesticides registered in Brazil in 2021 have been targeted at controlling plant-parasitic nematodes [7]. Hence, the submerged liquid fermentation may facilitate the scale-up while minimizing operational costs for the mass production of resilient propagules of these nematophagous fungal species, which could be well-suited to seed and soil applications.
Microsclerotia (MS) are dark-pigmented overwintering structures produced by some fungi under certain stress conditions and can be induced by submerged liquid cultivation. The MS exhibit a remarkable tolerance to abiotic/biotic stresses and excellent storability [53,54]. These traits make them very promising to agriculture, and their growth and nutritional requirements have been extensively studied, notably in Beauveria and Metarhizium [14,55,56,57]. In our work, the highest production of MS was achieved with high concentrations of carbon, with the C:N ratio of 50:1 (Jackson 6 medium), which is in agreement with the optimal production obtained for Trichoderma harzianum, with carbon content >25 g L−1 and C:N ratio from 10:1 to 50:1 [35]. The MS production seems to be triggered by the depletion of nitrogen, while carbon consumption induces the melanization process [14]. A lower C:N ratio led to more melanized MS at the end of the fermentation period (culture media Jackson 4 with 10:1 and modified Adamék in this study), although fewer were produced. Song et al. [54] observed that when culturing Metarhizium rileyi (formerly Nomuraea rileyi) in nitrogen and carbon-deficient liquid medium, no MS were formed, suggesting that a combination of the two nutrients is essential in the formation of this resting structure.
Microsclerotia (MS) comprise an alternative active ingredient to aerial conidia or environmentally sensitive submerged blastospores. The former is a resting fungal structure that may persist longer in soil than the latter. Generally, the soil antifungal activity can limit the persistence and survival of nematophagous fungi, thus influencing nematode control. Accordingly, propagules of P. chlamydosporia or P. lilacinum can be inhibited from germinating due to soil antifungal activity [58]. Microsclerotia (MS) of both nematophagous fungal species may be formulated for seed and soil treatments against plant-parasitic nematodes, and they may account for long persistence in the soil due to their natural resilience.
Blastospores are yeast-like vegetative single cells that are initially produced by hyphae in many situations, e.g., in the arthropod’s hemolymph [20]. This propagule can be produced in high concentrations by rich carbon-nitrogen liquid media and has the advantage of having a faster germination pace than aerial conidia [17,59,60]. Several biological control microorganisms can produce such cells, including Metarhizium [61], Beauveria, and Cordyceps [21,62,63]. To our knowledge, the production of these structures by P. lilacinum and P. chlamydosporia has not yet been reported. The production of submerged blastospores are greatly dependent on the concentrations of carbon and nitrogen in the liquid medium [16,18], which were present in the liquid media tested in this work. Romero-Rangel et al. [64] obtained 3.8 × 107 blastospores mL−1 of Hirsutella sp. in seven days; Jackson et al. [65] reported the production of 1 × 109 blastospores mL−1 for Cordyceps fumosorosea with four days of growth, changing only the nitrogen source. In contrast, the highest concentrations were achieved with the optimization of the submerged culture conditions by Mascarin et al. [21,62] Compared to earlier studies, our work assessed 42 isolates, of which some of them were able to produce blastospores at yields of up to 109 mL−1 in four days of cultivation, which would be expected for fast-growing propagules. The manipulation of the liquid medium plays a pivotal role in acquiring high concentrations of the desired propagule within shorter fermentation times and with the ability to endure osmotic/oxidative stress during desiccation [12]. It is therefore important to note that for the development and growth of these two fungal species, their different isolates may require different optimum nutritional and environmental conditions during submerged liquid fermentation. To this end, it is worthwhile to conduct additional research in order to understand better the nutritional and ecological requirements case-by-case for each fungal isolate.
In our research, common bean plants inoculated with P. lilacinum ESALQ1744, ESALQ2482, and ESALQ2593, and P. chlamydosporia ESALQ5405 and ESALQ5406 decreased the fecundity and, consequently, the population growth of the T. urticae population. Corroborating this result, Canassa et al. [38] reported suppression in the population growth of T. urticae after treating seeds of P. vulgaris with M. robertsii, B. bassiana, or both. The treatment of cotton seeds with P. lilacinum and B. bassiana decreased the survival of Helicoverpa zea [66]. Colonization of PGPFs could trigger the latent defense mechanisms within the plants, leading to systemic acquired resistance or induced systemic resistance, which are mediated by salicylic acid and jasmonic acid/ethylene, respectively [49,50]. Sometimes, plants undergo a state of “priming”, in which they are in a “state of alert”, and the mechanisms of resistance are more intensely expressed with the arrival of the stressor, and in a short time lapse [50]. However, the effect of endophytic (more specifically, the entomopathogenic fungi) is not limited to it. Notably, B. bassiana colonization in plants infected with Exserohilum turcicum increased the relative abundance of beneficial bacteria, such as Burkholderia and Pseudomonas [67]. The authors also reported that the microbiome complexity increased after treatment with B. bassiana. Recent studies have shown that soil and plant microbiomes play an important role in plant resilience against different sources of stress [68]. Therefore, it is noteworthy to highlight the importance of soil and plant microbiomes and the need for further investigations on the interactions between soil-plant microbiomes and endophytic colonization displayed by P. lilacinum and P. chlamydosporia in plant resilience and health challenged by abiotic and biotic stresses.
Our data revealed that some isolates of the nematophagous fungi tested were able to improve bean growth, while others were consistently effective in suppressing the cyst nematode population growth in bean plants. Particularly, the P. chlamydosporia isolate ESALQ5406 promoted a clear and pronounced growth effect on bean plants by boosting root development, and also proved to be a good endophyte. More interestingly, all nematophagous fungal isolates selected in this study strongly impaired the fecundity of T. urticae on the phyllosphere, which indicates that their endophytic association with bean plants can effectively trigger defense responses to aboveground attacks from phytophagous mites. To the best of our knowledge, this is the first time that isolates of P. lilacinum and P. chlamydosporia are reported to decrease the spider mite population growth in P. vulgaris plants whose seeds were inoculated with their MS. In the context of this tri-trophic interaction, our results tie well with previous studies, showing that seed inoculation with entomopathogenic fungal endophytes reduced spider mite population growth in bean plants [38,69]. This outcome is possibly related to defense responses against herbivores triggered by fungus-inoculated plants (e.g., proteins and secondary metabolites) and/or by the production of fungal secondary metabolites in planta [70,71]. Hence, it is possible that fungus-inoculated bean plants can either synthetize and accumulate toxic compounds to mites in leaf tissues, or that the fungus can also secrete internally acaricidal compounds that pose harmful effects on the mites. A snapshot of the molecular interactions of the endophytic growth of B. bassiana within the common bean plant (P. vulgaris) infested with T. urticae revealed the involvement of key fungal genes expressing degrading enzymes and sugar transporters [72]. Overall, the underlying biochemical and molecular mechanisms of these plant–fungus–mite and plant–fungus–nematode interactions require further in-depth investigations.
Regarding the H. glycines trials, the relatively low reproduction (below 1000 individuals/plant) could be due to the natural egg diapause, as previously described [73,74]. The method employed in this study for the extraction of nematode eggs has the advantage of retrieving a great number of eggs, but some of them may be in diapause. Nevertheless, in both experiments, we observed a decrease in the H. glycines reproduction by reducing the total number of nematodes per plant or gram of root. Both P. lilacinum and P. chlamydosporia are distinguished nematophagous fungi, as they are able to parasitize eggs, second-stage juveniles, mature females of sedentary nematodes, and cysts (e.g., Meloidogyne spp. and Heterodera spp.) [50,75,76] In addition, these fungi can trigger defense-related genes in the host and thus suppress plant-parasitic nematodes [58].
Only two fungal isolates, e.g., P. chlamydosporia ESALQ5406 and P. lilacinum ESALQ2593, consistently decreased the cyst nematode population in all greenhouse trials. However, it is noteworthy that all isolates (trial 1) and isolates ESALQ5405, ESALQ5406, and ESALQ2593 (Trial 2) diminished the number of nematodes per gram of root (Figure 7). In other words, although the final population is the same, proportionally (based on gram of roots), plants presented fewer nematodes due to a more developed root system. As discussed before, isolates of P. lilacinum and P. chlamydosporia increased the root mass at least in one occasion (Trial 2) (Figure 3). Taken together, we can confirm the increase in common bean root growth due to some fungal isolates. This could play a role in alleviating the damage caused by nematodes, as previously reported to PGPF [50].
Many studies have documented the successful biological control exerted by nematophagous fungi against plant-parasitic nematodes. For instance, Haaraith et al. [77] tested two Purpureocillium isolates (namely “E” and “T”) that suppressed the reproduction of H. glycines in soybean. In Abelmoschus esculentus ‘Sabz Pari’, P. lilacinum effectively reduced the number of galls, egg masses, and M. incognita reproduction [78]. Tomato plants colonized by P. chlamydosporia was found to infect and colonize galls and egg masses of M. javanica [79]. Other authors also reported the decrease of nematode per gram of root by biological control agents, which could be attributed to the various mechanisms of these fungi [5,80]. The production and delivery of leukine toxins, chitinases, proteases, and acetic acids are major factors of P. lilacinum suppression against phytonematodes [81,82]. In its turn, P. chlamydosporia secretes high amounts of chitinases and proteases and a plethora of secondary metabolites, which are important factors in its parasitism of sedentary nematode eggs and females [83]. The two most promising isolates of P. chlamydosporia and P. lilacinum selected here displayed strong suppression activities toward the population growth of both nematodes and spider mites in planta. Their probable mechanisms may involve the induction of plant defense mechanisms that can assist bean plants in alleviating the damage caused by either T. urticae or H. glycines attack.
The interactions between endophytic fungi and their hosts could lead to different outcomes, including growth promotion [84,85], increased nitrogen and carbon exchange [86], and even repellence activity against herbivorous insects, phytonematodes, and phytopathogenic fungi [87,88]. However, induced resistance is a prominent mechanism triggered by these fungi, which could negatively affect plant pathogens and pests [89,90,91]. This phenomenon involves the activation of latent defense mechanisms within plants, which are primarily mediated by salicylic acid and jasmonic acid [79]. The role of such mechanisms in the H. glycines/T. urticae × common bean interactions must be further elucidated.
5. Conclusions
Common bean seeds coated with MS of either P. lilacinum or P. chlamydosporia considerably reduced the population growth of the two-spotted spider mite T. urticae and negatively impacted on the population density of H. glycines. Notably, the isolates P. chlamydosporia ESALQ5406 and P. lilacinum ESALQ2593 provided the best results in suppressing spider mite and cyst nematode populations, which make them the strongest candidates for use in the management of these pests. These fungal isolates to some extent improved the growth of bean plants, and also endophytically colonized different parts of bean plants, although only P. lilacinum persisted in the soil. Endophytic fungi holding multifaceted roles in plant protection against phytophagous mites and plant-parasitic nematodes represent a valuable asset to be integrated into the management of T. urtice and H. glycines. In addition, the use of MS as the inoculum source for seed treatment is an innovative strategy that successfully promotes endophytic fungal growth within the host plant, which in turn can minimize their exposure to inconvenient abiotic factors towards a more persistent and cost-effective biocontrol agent. Fungal MS of P. chlamydosporia and P. lilacinum can be easily mass-produced and scaled-up through submerged liquid fermentation technology, thereby supporting the application of MS in seed treatment with fungal endophytes.
Our findings highlight a new perspective for applying nematophagous fungi to seed treatment by using a robust resting fungal propagule named miscrosclerotia (MS), which can be largely and rapidly produced by submerged liquid fermentation, thus promoting enhanced plant protection and health against below- and above-ground invertebrate pests.
Author Contributions
Conceptualization, D.M.S., G.M.M., I.D.J. and V.H.M.d.S.; methodology, D.M.S., G.M.M. and V.H.M.d.S.; formal analysis, D.M.S., G.M.M., R.d.A.M. and V.H.M.d.S.; software, G.M.M. and R.d.A.M.; resources, I.D.J.; writing—original draft preparation, D.M.S., G.M.M. and V.H.M.d.S.; writing—review and editing, D.M.S., G.M.M., I.D.J., R.d.A.M. and V.H.M.d.S.; supervision, I.D.J., G.M.M. and V.H.M.d.S.; project administration, D.M.S., G.M.M. and I.D.J.; funding acquisition, I.D.J. All authors have read and agreed to the published version of the manuscript.
Funding
D.M.S. was awarded with a fellowship from The National Council for Scientific and Technological Development (CNPq 132190/2018-4, from March 2018 to February 2020). I.D.J. is a recipient of CNPq productivity grants in research (PQ 312860/2021-8).
Institutional Review Board Statement
Not applicable.
Informed Consent Statement
Not applicable.
Data Availability Statement
Not applicable.
Acknowledgments
The first author thanks CAPES for the scholarship. We also thank the Laboratory of Nematology at ESALQ-USP for providing the nematode inoculum. All authors have consented these acknowledgments.
Conflicts of Interest
The authors declare no conflict of interest.
Appendix A

Figure A1.
Typical fungal propagules (blastospore and microsclerotium) produced by submerged liquid culture after four days of cultivation using shake flasks (50 mL of liquid medium and 300 rpm of agitation speed).

Figure A2.
Schematic illustration of the experimental procedure encompassing fungal seed treatment, greenhouse experimental setup, and root extraction for the determination of the final nematode population and nematodes per gram of fresh root mass (Figure created with BioRender.com (Accessed on 8 March 2021)).
References
- Eilenberg, J.; Hajek, A.E.; Lomer, C. Suggestions for unifying the terminology in biological control. BioControl 2001, 46, 387–400. [Google Scholar] [CrossRef]
- Parra, J.R.P. Biological control in Brazil: An overview. Sci. Agric. 2014, 71, 345–355. [Google Scholar] [CrossRef]
- Brito, D. Mercado de Biodefensivos Cresce Mais de 70% No Brasil em um ano. Ministério da Agricultura, Pecuária e Abastecimento 2019. Available online: www.agricultura.gov.br/noticias/feffmercado-de-biodefensivos-cresce-em-mais-de-50-no-brasil. (accessed on 3 January 2020).
- Lacey, L.A.; Grzywacz, D.; Shapiro-Ilan, D.I.; Frutos, R.; Brownbridge, M.; Goettel, M.S. Insect pathogens as biological agents: Back to the future. J. Invertebr. Pathol. 2015, 132, 1–41. [Google Scholar] [CrossRef] [PubMed] [Green Version]
- De Souza, V.H.M.; Inomoto, M.M.; Pascholati, S.F.; Roma-Almeida, R.C.C.; Melo, T.A.; Rezende, D.C. Fitonematoides: Controle Biológico e Indução de Resistência. In Revisão Anual de Patologia de Plantas, 1st ed.; Dalio, R.J.D., Ed.; Sociedade Brasileira de Fitopatologia: Brasília, Brazil, 2015; pp. 242–292. [Google Scholar]
- Mascarin, G.M.; Lopes, R.B.; Delalibera, Í.; Fernandes, É.K.K.; Luz, C.; Faria, M. Current Status and Perspectives of Fungal Entomopathogens Used for Microbial Control of Arthropod Pests in Brazil. J. Invertebr. Pathol. 2019, 165, 46–53. [Google Scholar] [CrossRef]
- Agrofif. Ministério da Agricultura, Pecuária e Abastecimento. 2020. Available online: http://agrofit.agricultura.gov.br/agrofit_cons/principal_agrofit_cons (accessed on 17 January 2020).
- Angelo, I.C.; Fernandes, E.K.K.; Bahiense, T.C.; Perinotto, W.M.S.; Golo, P.S.; Moraes, A.P.R.; Bittencourt, V.R.E. Virulence of Isaria sp. and Purpureocillium lilacinum to Rhipicephalus microplus tick under laboratory conditions. Parasitol. Res. 2012, 111, 1473–1480. [Google Scholar] [CrossRef]
- Medeiros, F.R.; Lemos, R.N.S.; Rodrigues, A.A.C.; Filho, A.B.; Oliveira, L.J.M.G.; Araujo, J.R.G. Occurrence of Purpureocillium lilacinum in citrus Black flynymphs. Rev. Bras. Frutic. 2018, 40, 1–3. [Google Scholar] [CrossRef] [Green Version]
- Maciá-Vicente, J.G.; Rosso, L.C.; Ciancio, A.; Lopez-Llorca, L.V. Colonisation of barley roots by endophytic Fusarion equiseti and Pochonia chlamydosporia: Effects on plant growth and disease. Ann. Appl. Biol. 2009, 155, 391–401. [Google Scholar] [CrossRef]
- Kiriga, A.W.; Haukeland, S.; Kariuki, G.M.; Coyne, D.L.; Beek, N.V. Effect of Trichoderma sand Purpureocillium lilacinum on Meloidogyne javanica in commercial pineapple production in Kenya. Biol. Control 2018, 119, 27–32. [Google Scholar] [CrossRef]
- Jaronski, S.T.; Mascarin, G.M. Chapter 9: Mass production of fungal entomopathogens. In Mass Production of Entomopathogenic Fungi: State of the Art; Jarinski, S.T., Ed.; Elsevier Inc.: Amsterdam, The Netherlands, 2017; pp. 141–155. [Google Scholar] [CrossRef]
- Jackson, M.A. Optimizing nutritional conditions for the liquid culture production of effective fungal biological control agents. J. Ind. Microbiol. Biotechnol. 1997, 19, 180–187. [Google Scholar] [CrossRef]
- Jackson, M.A.; Jaronski, S.T. Production of microsclerotia of the fungal entomopathogen Metarhizium anisopliae and their potential for use as a biocontrol agent for soil-inhabiting insects. Mycol. Res. 2009, 113, 842–850. [Google Scholar] [CrossRef]
- Thomas, K.C.; Khachatourians, G.G.; Ingledew, W.M. Production and properties of Beauveria bassiana conidia cultivated in submerged culture. Can. J. Microbiol. 1987, 33, 12–20. [Google Scholar] [CrossRef]
- Hegedus, D.D.; Bidochka, M.J.; Khachatourians, G.G. Beauveria bassiana submerged conidia production in a defined medium containing chitin, two hexosamines or glucose. Appl. Microbiol. Biotechnol. 1990, 33, 641–647. [Google Scholar] [CrossRef]
- Cho, E.M.; Liu, L.; Farmerie, W.; Keyhani, N.O. EST analysis of cDNA libraries from entomopathogenic fungus Beauveria (Cordyceps) bassiana. I. Evidence for stage-specific gene expression in aerial conidia, in vitro blastospores and submerged conidia. Microbiology 2006, 152, 2843–2854. [Google Scholar] [CrossRef] [PubMed] [Green Version]
- Bidochka, M.J.; Pfeifer, T.A.; Khachatourians, G.G. Development of the entomopathogenic fungus Beauveria bassiana in liquid cultures. Microbiology 1987, 99, 77–83. [Google Scholar] [CrossRef]
- Humphreys, A.M.; Matewele, P.; Trinci, A.P.J.; Gillespie, A.T. Effects of water activity on morphology, growth and blastospore production of Metarhizium anisopliae, Beauveria bassiana and Paecilomyces farinosus in batch and fed-batch culture. Mycol. Res. 1989, 92, 257–264. [Google Scholar] [CrossRef]
- Feng, M.G.; Poprawski, T.J.; Khachatourians, G.G. Production, formulation and application of the entomopathogenic fungus Beauveria bassiana for insect control worldwide. Biocontrol Sci. Technol. 1994, 4, 34. [Google Scholar] [CrossRef]
- Mascarin, G.M.; Jackson, M.A.; Kobori, N.N.; Behle, R.W.; Dunlap, C.A.; Delalibera Júnior, Í. Glucose concentration alters dissolved oxygen levels in liquid cultures of Beauveria bassiana and affects formation and bioefficacy of blastospores. Appl. Microbiol. Biotechnol. 2015, 99, 6653–6665. [Google Scholar] [CrossRef]
- De Lira, A.C.; Mascarin, G.M.; Delalibera Júnior, Í. Microsclerotia production of Metarhizium sfor dual role as plant biostimulant and control of Spodoptera frugiperda through corn seed coating. Fungal Biol. 2020, 124, 689–699. [Google Scholar] [CrossRef]
- Marciano, A.F.; Mascarin, G.M.; Franco, R.F.F.; Golo, P.S.; Jaronski, S.T.; Fernandes, É.K.K.; Bittencourt, V.R.E.P. Innovative granular formulation of Metarhizium robertsii microsclerotia and blastospores for cattle tick control. Sci. Rep. 2021, 11, 4972. [Google Scholar] [CrossRef]
- Santos, T.R.; da Paixão, F.R.S.; Catão, A.M.L.; Muniz, E.R.; Ribeiro-Silva, C.S.; Taveira, S.F.; Luz, C.; Mascarin, G.M.; Fernandes, É.K.K.; Marreto, R.N. Inorganic pellets containing microsclerotia of Metarhizium anisopliae: A new technological platform for the biological control of the cattle tick Rhipicephalus microplus. Appl. Microbiol. Biotechnol. 2021, 105, 5001–5012. [Google Scholar] [CrossRef]
- Ferreira, C.; Andrade, F.; Rodrigues, A.; Siqueira, H.; Gondim, M., Jr. Resistance in field populations of Tetranychus urticae to acaricides and characterization of the inheritance of abamectin resistance. Crop. Prot. 2015, 67, 77–83. [Google Scholar] [CrossRef]
- Suekane, R.; Degrande, P.E.; Melo, E.P.; Bertoncello, T.F.; Junior, I.S.L.; Kodama, C. Damage level of the two-spotted spider mite Tetranychus urticae Koch (Acari: Tetranychidae) in soybeans. Rev. Ceres 2012, 59, 77–81. [Google Scholar] [CrossRef]
- Wrather, J.A.; Stienstra, W.C.; Koenning, S.R. Soybean disease loss estimates for the United States from 1996 to 1998. Can. J. Plant Pathol. 2001, 23, 122–131. [Google Scholar] [CrossRef]
- Morton, C.O.; Mauchline, T.H.; Kerry, R.; Hirsch, P.R. PCR-based DNA fingerprinting indicates host-related genetic variation in the nematophagous fungus Pochonia chlamydosporia. Mycol. Res. 2003, 107, 198–205. [Google Scholar] [CrossRef]
- Medina-Canales, M.G.; Rodríguez-Tovar, A.V.; Manzanilla-López, R.H.; Zuniga, G.; Tovar-Soto, A. Identification and molecular characterisation of new Mexican isolates of Pochonia chlamydosporia for the management of Meloidogyne spp. Biocontrol Sci. Technol. 2014, 24, 1–21. [Google Scholar] [CrossRef]
- Sequeira, D.C.M.; Menezes, R.C.; Oliveira, M.M.E.; Antas, P.R.Z.; Luca, P.M.; Oliveira-Ferreira, J.; Borba, C.M. Purpureocillium lilacinum: Outcome of the infection in C57BL/6 MurineModels. Front. Microbiol. 2014, 8. [Google Scholar] [CrossRef] [Green Version]
- Kimura, M. A simple method for estimating evolutionary rate of base substitutions through comparative studies of nucleotides sequences. J. Mol. Evol. 1980, 16, 11–120. [Google Scholar] [CrossRef]
- Tamura, K.; Stecher, G.; Peterson, D.; Filipski, A.; Kumar, S. MEGA6: Molecular evolutionary genetics analysis version 6.0. Mol. Biol. Evol. 2013, 30, 2725–2729. [Google Scholar] [CrossRef] [Green Version]
- Iwanicki, N.S.; Ferreira, B.O.; Mascarin, G.M.; Delalibera, I. Modified Adamek’s medium renders high yields of Metarhizium robertsii blastospores that are desiccation tolerant and infective to cattle-tick larvae. Fungal Biol. 2018, 122, 883–890. [Google Scholar] [CrossRef]
- Adámek, L. Submerse cultivation of the fungus Metarhizium anisopliae (Metsch.). Folia Microbiol. 1965, 10, 255–257. [Google Scholar] [CrossRef]
- Kobori, N.N.; Mascarin, G.M.; Jackson, M.A.; Schilser, D.A. Liquid culture production of microsclerotia and submerged conidia by Trichoderma harzianum active against damping-off disease caused by Rhizoctonia solani. Fungal Biol. 2015, 119, 179–190. [Google Scholar] [CrossRef] [PubMed] [Green Version]
- Akutse, K.S.; Maniania, N.K.; Fiaboe, K.K.M.; Van Den Berg, J.; Ekesi, S. Endophytic colonization of Vicia faba and Phaseolus vulgaris (Fabaceae) by fungal pathogens and their effecys on the life-history parameters of Liriomyza huidobrensis (Diptera: Agromyzidae). Fungal Ecol. 2013, 6, 293–301. [Google Scholar] [CrossRef]
- Behie, S.W.; Jones, S.J.; Bidochka, M.J. Plant tissue localization of the endophytic insect pathogenic fungi Metarhizium and Beauveria. Fungal Ecol. 2015, 13, 112–119. [Google Scholar] [CrossRef]
- Canassa, F.; Tall, S.; Moral, R.A.; Lara, I.A.R.; Delalibera, I.; Meyling, N.V. Effects of bean seed treatment by the entomopathogenic fungi Metarhizium robertsii and Beauveria bassiana on plant growth, spider mite population and behavior of predatory mites. Biol. Control 2019, 132, 199–208. [Google Scholar] [CrossRef]
- Machado, A.; Silva, S.A. Extração de nematoides. In Métodos em Nematologia Agrícola. Sociedade Brasileira de Nematologia; Machado, A.C.Z., Silva, S.A., Ferraz, L.C.C.B., Eds.; Sociedade Brasileira de Nematologia: Piracicaba, Brazil, 2019; pp. 9–33. [Google Scholar]
- Niblack, T.L. Soybean cyst nematode management reconsidered. Plant Dis. 2005, 89, 1020–1026. [Google Scholar] [CrossRef] [Green Version]
- Coolen, W.A.; D’Herde, C.J. A Method for the Quantitative Extraction of Nematodes from Plant Tissue, 1st ed.; State Agriculture Research Center: Ghent, Belgium, 1972; p. 77. [Google Scholar]
- Warnes, G.R.; Bolker, B.; Bonebakker, L.; Gentleman, R.; Liaw, W.H.A.; Lumley, T.; Maechler, M.; Magnusson, A.; Moeller, S.; Schwartz, M.; et al. Gplots: Various R Programming Tools for Plotting Data. R Package Version 3.0.1.2. 2020. Available online: https://CRAN.R-project.org/package=gplots (accessed on 5 December 2021).
- Lenth, R.V. Emmeans: Estimated Marginal Means, Aka Least-Squares Means [Computer Software Manual]. (R package version 1.4.1). 2020. Available online: http://cran.project.org/package=emmeans (accessed on 5 December 2021).
- Stasinopoulos, D.M.; Rigby, R.A. Generalized additive models for location scale and shape (GAMLSS) in R. J. Stat. Softw. 2007, 23, 1–46. Available online: http://www.jstatsoft.org/v23/i07 (accessed on 5 December 2021). [CrossRef] [Green Version]
- Moral, R.; Hinde, J.; Demétrio, C. Half-Normal plots and overdispersed models in R: The hnp package. J. Stat. Softw. 2017, 81, 1–23. [Google Scholar] [CrossRef] [Green Version]
- R Core Team. R: A language and environment for statistical computing. R. Foundation for Statistical Computing. 2021. Available online: https://www.R-project.org/ (accessed on 5 December 2021).
- Sun, T.; Wu, J.; Ali, S. Morphological and molecular identification of four Purpureocillium isolates and evaluating their efficacy against the sweet potato whitefly, Bemisia tabaci (Genn.) (Hemiptera: Aleurodidae). Egyp. J. Biol. Pest Control 2021, 31, 27. [Google Scholar] [CrossRef]
- Giaretta, R.D. Isolamento, Identificação e Avaliação de Pochonia chlamudosporia No Controle de Meloidogyne javanica e na Promoção de Crescimento de Tomateiro. Ph.D. Thesis, Universidade Feferal de Viçosa, Viçosa, Brazil, 2008. Available online: https://www.locus.ufv.br/bitstream/123456789/1012/1/texto%20completo.pdf (accessed on 21 February 2022).
- Hossain, M.M.; Sultana, F.; Islam, S. Plant Growth-Promoting Fungi (PGPF): Phytostimulation and Induced Systemic Resistance. In Plant-Microbe Interactions in Agro-Ecological Perspectives, 1st ed.; Singh, D.P., Singh, H.B., Prabha, R., Eds.; Springer: Singapore, 2017; Volume 2, pp. 135–191. [Google Scholar] [CrossRef]
- Fontana, D.C.; de Paula, S.; Torres, A.G.T.; de Souza, V.H.M.; Pascholati, S.F.; Schmidt, D.; Neto, D.D. Endophytic Fungi: Biological Control and Induced Resistance to Phytopathogens and Abiotic Stresses. Pathogens 2021, 10, 570. [Google Scholar] [CrossRef]
- Yang, L.; Zou, Y.N.; Tian, Z.H.; Wu, Q.S.; Kuča, K. Effects of beneficial endophytic fungal inoculants on plant growth and nutrient absorption of trifoliate orange seedlings. Sci. Hortic. 2021, 227, 109815. [Google Scholar] [CrossRef]
- Song, Z.; Shen, L.; Zhong, Q.; Yin, Y.; Wang, Z. Liquid culture production of microsclerotia of Purpureocillium lilacinum for use as bionematicide. Nematology 2016, 18, 719–726. [Google Scholar] [CrossRef]
- Behle, R.W.; Jackson, M.A. Effect of Fermentation Media on the Production, Efficacy, and Storage Stability of Metarhizium brunneum Microsclerotia Formulated as a Prototype Granule. J. Econ. Entomol. 2014, 107, 582–590. [Google Scholar] [CrossRef] [PubMed]
- Song, Z.; Yin, Y.; Jiang, S.; Liu, J.; Wang, Z. Optimization of culture medium for microsclerotia production by Nomuraea rileyi and analysis of their viability for use as a mycoinsecticide. BioControl 2014, 59, 597–605. [Google Scholar] [CrossRef]
- Mascarin, G.M.; Kobori, N.N.; Vital, R.C.J.; Jackson, M.A.; Quintela, E.D. Production of microsclerotia by Brazilian strains of Metarhizium susing submerged liquid culture fermentation. World J. Microbiol. Biotechnol. 2014, 30, 1583–1590. [Google Scholar] [CrossRef]
- Zhou, G.; Song, Z.; Yin, Y.; Jiang, W.; Wang, Z. Involvement of an alternative oxidase in the regulation of hyphal growth and microsclerotial formation in Nomuraea rileyi CQNr01. World J. Microbiol. Biotechnol. 2015, 31, 1343–1352. [Google Scholar] [CrossRef] [PubMed]
- Song, Z. Fungal microsclerotia development: Essential prerequisites, influencing factors, and molecular mechanism. Appl. Microbiol. Biotechnol. 2018, 102, 9873–9880. [Google Scholar] [CrossRef]
- Larriba, E.; Jaime, M.D.L.A.; Nislow, C.; Martín-Nieto, J.; Lopez-Llorca, L.V. Endophytic colonization of barley (Hordeum vulgare) roots by nematophagous fungus Pochonia chlamydosporia reveals plant growth promotion and a general defense and stress transcriptomic response. J. Plant Res. 2015, 128, 665–678. [Google Scholar] [CrossRef]
- Vega, F.E.; Jackson, M.A.; McGuire, M.R. Germination of conidia and blastospores of Paecilomyces fumosoroseus on the cuticle of the silverleaf whitefly, Bemisia argentifolii. Mycopathologia 1999, 147, 33–35. [Google Scholar] [CrossRef]
- Bernardo, C.C.; Barreto, L.P.; Silva, C.S.R.; Luz, C.; Arruda, W.; Fernandes, É.K.K. Conidia and blastospores of Metarhizium sand Beauveria bassiana s.l.: Their development during the infection process and virulence against the tick Rhipicephalus microplus. Ticks Tick Borne Dis. 2018, 9, 1334–1342. [Google Scholar] [CrossRef]
- Iwanicki, N.S.; Delalibera Júnior, I.; Eilenberg, J.; Licht, H.H.D.F. Comparative RNAseq analysisis of the insect-pathogenic fungus Metarhizium anisopliae reverals specific transcriptome signatures of finalmentous and yeast-like development. G3 Genes Genomes Genet. 2020, 10, 2141–2157. [Google Scholar] [CrossRef]
- Mascarin, G.M.; Jackson, M.A.; Kobori, N.N.; Behle, R.W.; Delalibera Junior, I. Liquid culture fermentation for rapid production of desiccation tolerant blastospores of Beauveria bassiana and Isaria fumosorosea strains. J. Invertebr. Pathol. 2015, 127, 11–20. [Google Scholar] [CrossRef] [PubMed]
- Corrêa, B.; da Silveira Duarte, V.; Silva, D.M.; Mascarin, G.M.; Júnior, I.D. Comparative analysis of blastospore production and virulence of Beauveria bassiana and Cordyceps fumosorosea against soybean pests. BioControl 2020, 65, 323–337. [Google Scholar] [CrossRef]
- Romero-Rangel, O.; Maldonado-Blanco, M.G.; Aguilar-López, C.C.; Elías-Santos, M.; Rodríguez-Guerra, R.; López-Arroyo, J.I. Production of mycelium and blastospores of Hirsutella sp. in submerged culture. Afr. J. Biotechnol. 2012, 11, 15336–15340. [Google Scholar] [CrossRef]
- Jackson, M.A.; Cliquet, S.; Iten, L.B. Media and Fermentation process for the rapid production of high concentrations of stable blastospores of the bioinsecticidal fungus Paecilomyces fumosoroseus. Biocontrol Sci. Technol. 2003, 13, 23–33. [Google Scholar] [CrossRef]
- Lopez, D.C.; Sword, G.A. The endophytic fungal entomopathogens Beauveria bassiana and Purpureocillium lilacinum enhance the growth of cultivated cotton (Gossypium hirsutum) and negatively affect survival of the cotton bollworm (Helicoverpa zea). Biol. Control 2015, 89, 53–60. [Google Scholar] [CrossRef]
- Chang, Y.; Xia, X.; Sui, L.; Kang, Q.; Lu, Y.; Li, L.; Liu, W.; Li, Q.; Zhang, Z. Endophytic colonization pf entomopathogenic fungi increases plant disease resistance by changing the endophytic bacterial community. J. Basic Microbiol. 2021, 61, 1098–1112. [Google Scholar] [CrossRef]
- Dini-Andreote, F. Endophytes: The Second Layer of Plant Defense. Trends Plant Sci. 2020, 25, 319–322. [Google Scholar] [CrossRef]
- Dash, C.K.; Bamisile, B.S.; Keppanan, R.; Qasim, M.; Lin, Y.W.; Ul Islam, S.; Hussain, M.; Wang, L.D. Endophytic entomopathogenic fungi enhance the growth of Phaseolus vulgaris L. (Fabaceae) and negatively affect the development and reproduction of Tetranychus urticae Koch (Acari: Tetranychidae). Microb. Pathog. 2018, 125, 385–392. [Google Scholar] [CrossRef]
- Golo, P.S.; Gardner, D.R.; Grilley, M.M.; Takemoto, J.Y.; Krasnoff, S.B.; Pires, M.S.; Fernandes, E.K.K.; Bittencourt, V.R.E.P.; Roberts, D.W. Production of destruxins from Metarhizium sfungi in artificial medium and in endophytically colonized cowpea plants. PLoS ONE 2017, 9, e104946. [Google Scholar] [CrossRef]
- Garrido-Jurado, I.; Resquín-Romero, G.; Amarilla, S.P.; Ríos-Moreno, A.; Carrasco, L.; Quesada-Moraga, E. Transient endophytic colonization of melon plants by entomopathogenic fungi after foliar application for the control of Bemisia tabaci Gennadius (Hemiptera: Aleyrodidae). J. Pest Sci. 2017, 90, 319–330. [Google Scholar] [CrossRef]
- Al Khoury, C. Molecular insight into the endophytic growth of Beauveria bassiana within Phaseolus vulgaris in the presence or absence of Tetranychus urticae. Mol. Biol. Rep. 2021, 48, 2485–2496. [Google Scholar] [CrossRef] [PubMed]
- Hill, N.S.; Schmitt, D.P. Influence of temperature and soybean phenology on dormancy induction in Heterodera glycines. J. Nematol. 1989, 2, 361–369. [Google Scholar]
- Yen, J.H.; Niblack, T.; Wiebold, W.J. Dormancy of Heterodera glycines in Missouri. J. Nematol. 1995, 27, 153–163. [Google Scholar] [PubMed]
- Westphal, A.; Becker, J.O. Components of soil suppressiveness against Heterodera schachtii. Soil Biol. Biochem. 2001, 33, 9–16. [Google Scholar] [CrossRef]
- Silva, S.D.; Carneiro, R.M.D.G.; Faria, M.; Souza, D.A.; Monnerat, R.G.; Lopes, R.B. Evaluation of Pochonia chlamydosporia and Purpureocillium lilacinum for Suppression of Meloidogyne enterolobii on Tomato and Banana. J. Nematol. 2017, 49, 77–85. [Google Scholar] [CrossRef] [Green Version]
- Haarith, D.; Kim, D.; Chen, S.; Bushley, K.E. Growth chamber and greenhouse screening of promising in vitro fungal biological control candidates for the soybean cyst nematode (Heterodera glycines). Biol. Control 2021, 160, 104635. [Google Scholar] [CrossRef]
- Mukhtar, T.; Arshad Hussain, M.; Zameer Kayani, M. Biocontrol potential of Pasteuria penetrans, Pochonia chlamydosporia, Paecilomyces lilacinus and Trichoderma harzianum against Meloidogyne incognita in okra. Phytopathol. Mediterr. 2013, 52, 66–76. [Google Scholar] [CrossRef]
- Escudero, N.; Lopez-Llorca, L.V. Effects on plant growth and root-knot nematode infection of an endophytic GFP transformant of the nematophagous fungus Pochonia chlamydosporia. Symbiosis 2012, 57, 33–42. [Google Scholar] [CrossRef]
- Burkett-Cadena, M.; Kokalis-Burelle, N.; Lawrence, K.S.; Van Santen, E.; Kloepper, J.W. Suppressiveness of root-knot nematodes mediated by rhizobacteria. Biol. Control 2008, 47, 55–59. [Google Scholar] [CrossRef]
- Holland, R.J.; Williams, K.L.; Khan, A. Infection of Meloidogyne javanica by Paecilomyces lilacinus. Nematology 1999, 1, 131–139. [Google Scholar] [CrossRef]
- Kiewnick, S.; Sikora, R.A. Biological control of the root-knot nematode Meloidogyne incognita by Paecilomyces lilacinus strain 251. Biol. Control 2006, 38, 179–187. [Google Scholar] [CrossRef]
- Huang, X.W.; Zhao, N.H.; Zhang, K.Q. Extracellular enzymes serving as virulence factors in nematophagous fungi involved in infection of the host. Res. Microbiol. 2004, 55, 811–816. [Google Scholar] [CrossRef] [PubMed]
- Parsa, S.; Adriana, M.; García-Lemos, K.C.; Ortiz, V.; López-Lavalle, L.A.B.; Braun, J.; Vega, F.E. Fungal Endophytes in Germinated Seeds of the Common Bean, Phaseolus vulgaris. Fungal Biol. 2016, 120, 783–790. [Google Scholar] [CrossRef] [PubMed] [Green Version]
- Russo, M.L.; Pelizza, S.A.; Vianna, M.F.; Allegrucci, N.; Cabello, M.N.; Toledo, A.V.; Mourelos, C.; Scorsetti, A.C. Effect of endophytic entomopathogenic fungi on soybean Glycine max (L.) Merr. growth and yield. J. King Saud Univ. 2018, 31, 728–736. [Google Scholar] [CrossRef]
- Parniske, M. Arbuscular mycorrhiza: The mother of plant root endosymbioses. Nat. Rev. Microbiol. 2008, 6, 763–775. [Google Scholar] [CrossRef] [PubMed]
- Schardl, C.L.; Leuchtmann, A.; Spiering, M.J. Symbioses of grasses with seedborne fungal endophytes. Annu. Rev. Plant Biol. 2004, 55, 315–340. [Google Scholar] [CrossRef] [PubMed]
- Jaber, L.R.; Ownley, B.H. Can we use entomopathogenic fungi as endophytes for dual biological control of insect pests and plant pathogens? Biol. Control 2018, 116, 36–45. [Google Scholar] [CrossRef]
- Barros, F.C.; Sagata, É.; de Castro Ferreira, L.C.; Juliatti, F.C. Induction of resistance in plants against phytopathogens. Biosci. J. 2010, 26, 231–239. [Google Scholar]
- Pascholati, S.F.; Souza, V.H.M.; Cardoso Filho, J.A. Indução de Resistência Por Trichoderma. In Uso de Trichoderma Na Agricultura; Pascholati, S.F., Souza, V.H.M., Cardoso Filho, J.A., Eds.; Embrapa Soja: Londrina, Brazil, 2019; Volume 1, pp. 241–258. [Google Scholar]
- Ruan, J.; Zhou, Y.; Zhou, M.; Yan, J.; Khyrshid, M.; Weng, W.; Cheng, J.; Zhang, K. Jasmonic acid signaling pathway in plants. Int. J. Mol. Sci. 2019, 20, 2479. [Google Scholar] [CrossRef] [Green Version]
Publisher’s Note: MDPI stays neutral with regard to jurisdictional claims in published maps and institutional affiliations. |
© 2022 by the authors. Licensee MDPI, Basel, Switzerland. This article is an open access article distributed under the terms and conditions of the Creative Commons Attribution (CC BY) license (https://creativecommons.org/licenses/by/4.0/).